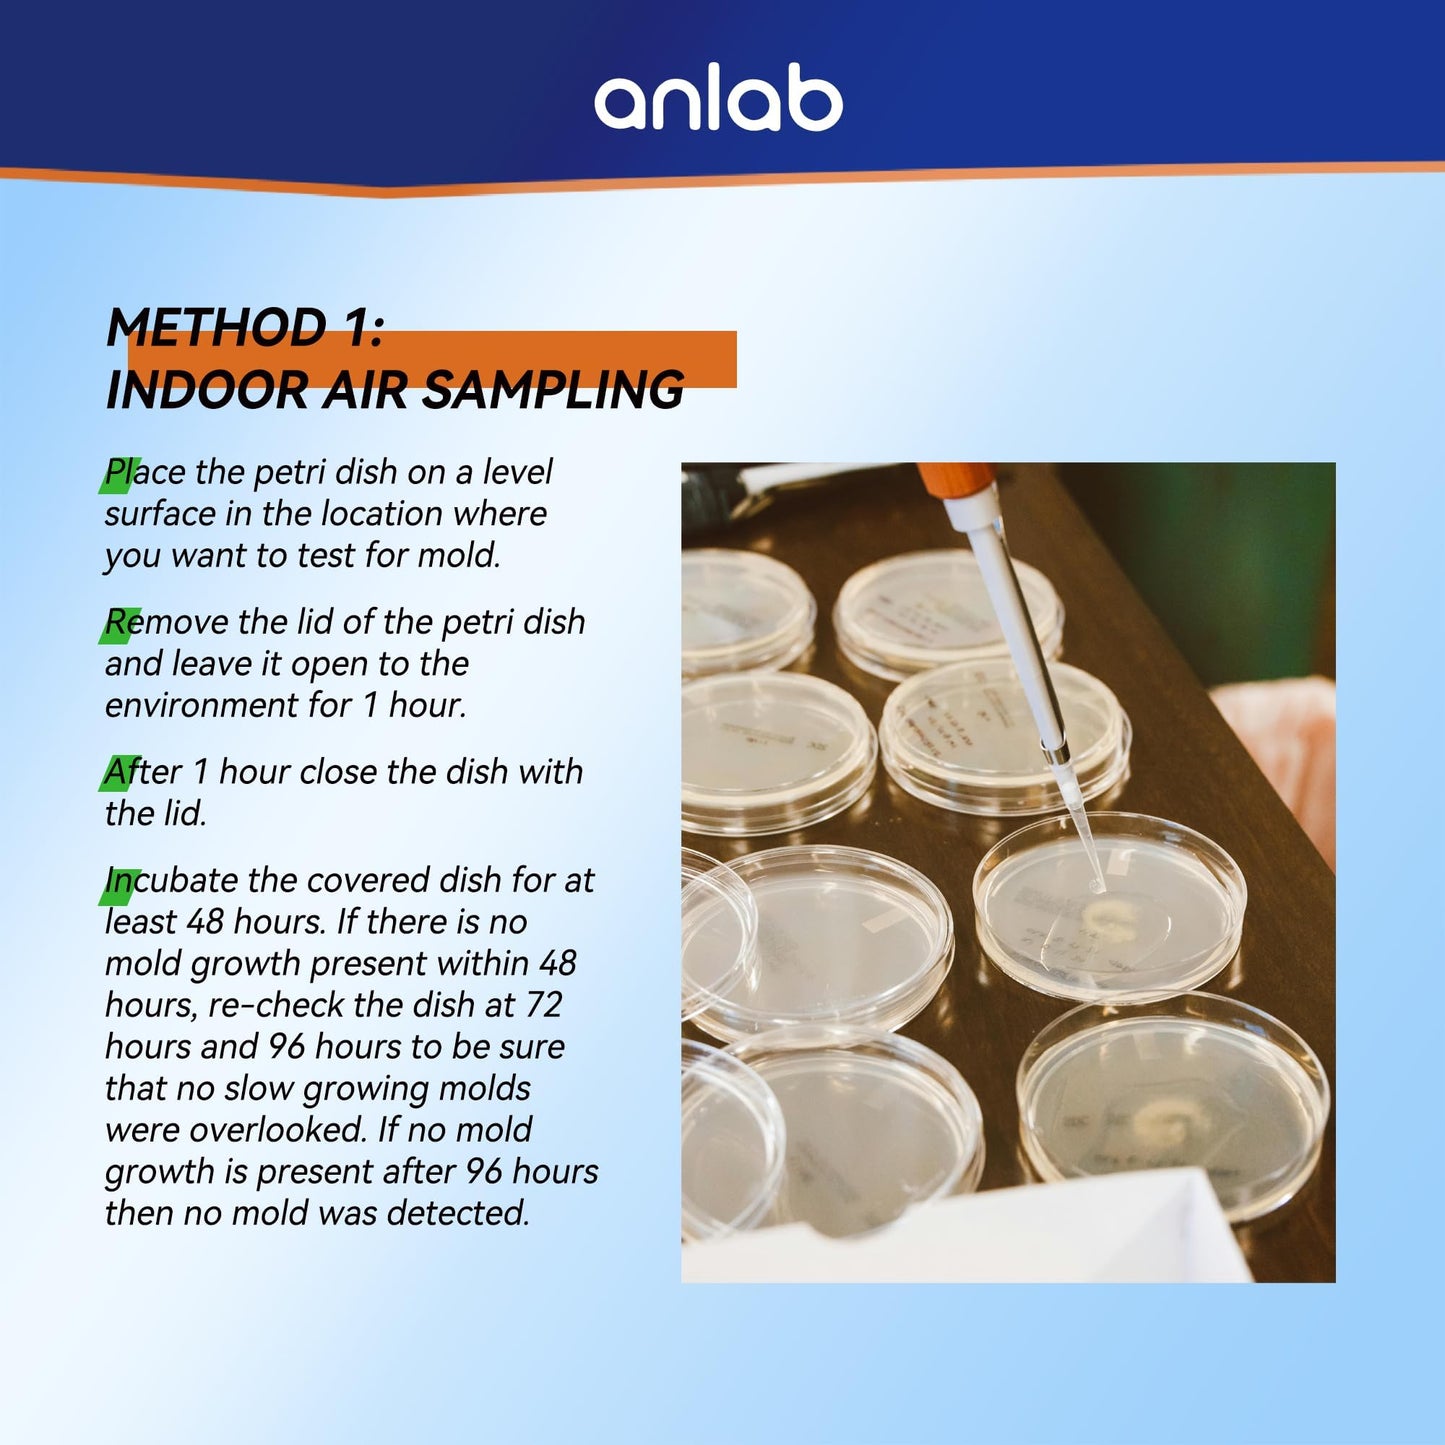

1
/
of
14
anlab
anlab™Mold Test Kit for Home - Do It Yourself Home Mold Detector | Test HVAC System | Home Surfaces | Indoor Air Quality Testing Kit - Identification Guide Included - Sealed Separately
anlab™Mold Test Kit for Home - Do It Yourself Home Mold Detector | Test HVAC System | Home Surfaces | Indoor Air Quality Testing Kit - Identification Guide Included - Sealed Separately
Regular price
£18.00 GBP
Regular price
Sale price
£18.00 GBP
Taxes included.
Quantity
Couldn't load pickup availability
- OUR DIFFERENCES: anlab's products are individually sealed. With each plate & cotton swab having a separate sealed packaging. This way, you can open a certain plate according to your own arrangement, while other plates are completely unaffected. Other brands' products are sealed together in multiple containers, so once the packaging is opened, all the plates must be used up, otherwise the products will soon expire and become ineffective.
Share